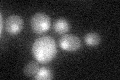
YER162C
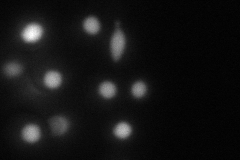
YER162C
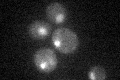
YER162C

View description
Protein that recognizes and binds damaged DNA (with Rad23p) during nucleotide excision repair; subunit of Nuclear Excision Repair Factor 2 (NEF2); homolog of human XPC protein
Localization:
Intensity:
Fold change:
Significance:
-
C’ GFP library in SD
nucleus19.22 -
N' NOP1pr-GFP in SD

nucleus53.5485 -
N' TEF2pr-mCherry in SD
nucleus51.7219 -
N' NATIVEpr-GFP in SD

nucleus23.3508 -
N' TEF2pr-VC and Cyto-VN in SD

nucleus28.0406 -
C’ GFP library in SD+DTT

nucleus23.261.21No -
C’ GFP library in SD+H2O2

nucleus22.051.14No -
C’ GFP library in Starvation Media
nucleus21.421.11No -
C’ GFP library on the background of Pup2-DaMP

nucleus -
C’ GFP library on the background of CCT mutant

nucleus21.14521.09988No
